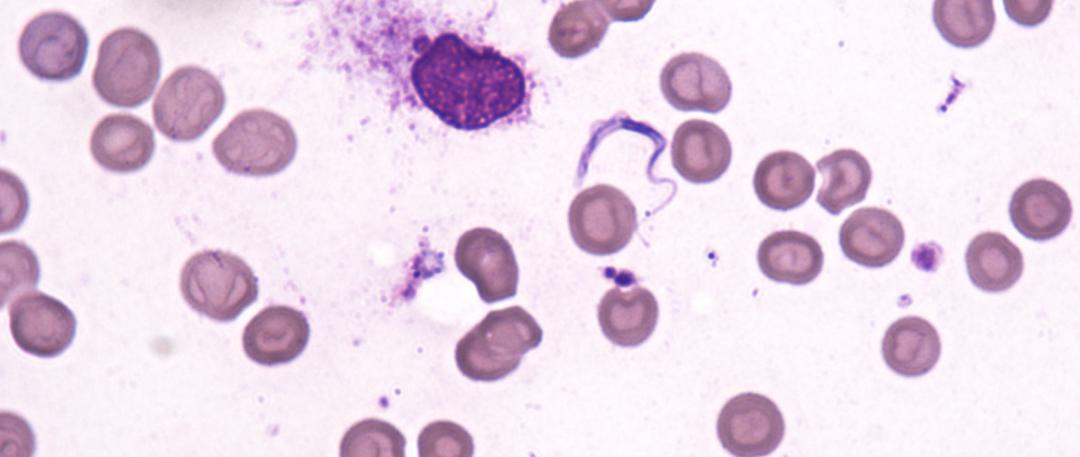
51岁老刘臀部包块不断长大，华山感染专家：是非洲来的“偷渡客”

人生不止眼前的苟且,还有诗和远方。
非洲,一个古老而遥远的地方,撒哈拉、尼罗河、金刚石、非洲象、原始森林,除了这些,还有什么等待着每一个外来客?
不明包块,从何而来
时间回溯到2017年末,51岁的老刘来到华山医院就诊。那年秋天开始,一个不大不小的问题给他带来了困扰。
一天,他无意中发现左臀上出现了一个小包块,约摸黄豆大小,不疼不痒,局部也没有红肿,尝试推也推不动。不久后,身上还开始出现红色的皮疹,最开始在双侧大腿上,而后全身泛发,但不久便自行消退了。因为身体并无其余不适,没有发热咳嗽,也没有头痛、关节痛,他便没当回事。
谁知,这个小小的包块竟悄悄地一天天“长大”了,这让他不由得担心了起来。一个月前,他到当地医院检查了血常规、尿常规、粪常规、肝肾功能和肿瘤标志物,但均没有异常。
老刘不放心,进一步转诊至上级三甲医院再检查,B超提示左侧臀部皮下低回声区(27×15×18mm),炎症性可能,左侧臀部皮下水肿。医生考虑这可能是一个炎症性包块,建议老刘将其切除,并通过活检明确病因。老刘爽快答应。
病理结果不久就出来了:标本为寄生虫感染性炎性增生结节,可见寄生虫虫体!这下可把老刘吓坏了:没想到这个小小包块里竟然藏着寄生虫!在他的印象里,寄生虫应该是经常吃生肉的人的才容易得,自己并没有吃生肉,怎么就感染上了寄生虫呢?而这到底是什么虫?
能治的好吗?还有其他地方有虫吗?老刘内心充满疑问,惴惴不安。
追踪溯源,端倪始现
面对忧心忡忡的老刘,当地医院医生建议他:如果你想尽快搞清病情,那到上海华山医院感染科去看看吧。
2017年11月底,老刘带着病理结果赶赴上海,先在华山医院感染科门诊挂号就诊,初步检查了一些常规化验:血常规、血沉等,粪便里找寄生虫虫卵,除了嗜酸性粒细胞轻度升高之外,未见明显病原学证据。进一步检查寄生虫抗体,结果显示曼氏裂头蚴抗体阳性。
难道就是曼氏裂头蚴感染?不,还不能确定。
因为寄生虫的血清学检测,通常可能出现交叉反应而致假阳性。光凭抗体结果仍不能对感染的虫种下定论,要查出这位“偷渡客”的真实身份,还需要进一步确认。
另外,虽然患者目前只出现了皮下包块这一临床表现,无法排除其他器官是否被寄生虫累及,如果不进行全面检查,日后很可能会出现严重影响生活的并发症。综合评估后,门诊接诊医生建议老刘入院。
入院检查

查体
T:36.8℃,P:72次/分,R:18次/分,BP:113/82mmHg,神志清,精神可,营养发育正常,自主体位,步入病房,查体合作,对答切题。浅表淋巴结未触及。左侧臀部术后疤痕,愈合良好,未见红肿、渗出、流脓。心肺无殊,腹部平软,全腹无压痛、反跳痛,肝脾肋下未及,双下肢不肿。

辅助检查
2017年12月11日实验室检查:
血常规:白细胞计数:7.41×10^9/L,红细胞计数:5.2×10^12/L,血红蛋白:154g/L,中性粒细胞%:65.6%,淋巴细胞%:25.1%,单核细胞%:5%,嗜酸性粒细胞%:3.9%,嗜碱性粒细胞%:0.4%,血小板计数:270×10^9/L。嗜伊红细胞:286×10^6/L;血沉:2mm/h;降钙素原:0.02ng/mL;C反应蛋白:<3.03mg/L。肝肾功能、电解质、凝血功能:正常。尿常规:正常;粪常规:正常,粪便找虫卵:阴性。血涂片找疟原:未找到。
2017年12月11日胸部CT扫描:右上肺小结节,考虑纤维硬结灶可能,随访;两下肺少许纤维灶。
2017年12月14日手术部位超声提示:左侧臀部切口处皮下低弱回声团块,符合术后改变。腹部超声提示:脂肪肝。胆囊、胰腺、脾脏、双肾未见明显异常。
老刘收入感染科病房,住在了专门研究旅行医学与热带病学的王新宇老师带领的组里。王老师又开始对患者进行仔细的“盘问”,希望能找出“偷渡客”的庐山真面目。
对于寄生虫感染的患者来说,询问其旅居史是非常重要的,不同地区的寄生虫种类有所不同,而患者何时、去过什么地方,滞留多长时间,是否有暴露史等,都是需要我们重点关注的部分。
王老师查房时问刚来我科实习的实习医生:“大家知道国内有哪些寄生虫的流行区域吗?来讲讲。”实习医生眼珠左右转着,没接话。
王老师开始侃侃而谈:“我国流行最严重的寄生虫病,应该是食源性的,所谓病从口入。如广州管圆线虫,多是寄生在福寿螺等螺类体内,当地人常常为了尝鲜,仅是把螺肉烫一下就吃了,说是味道鲜美,但是也把管圆线虫吃进肚子里了。但随着物流的发达,鲜美的福寿螺,当天就可以运到福寿螺没有自然分布的地区,比如北京,从而引起管圆线虫病在非流行区域的散发病例或者小暴发。”
王老师继续说道:“大家知道寄生虫的易感人群情况吗?” 周围有点安静。“还是我来说哈,根据我们寄生虫调查报告,从职业上来看,蛔虫感染是学生最高;钩虫、肝吸虫是半农半商的菜农感染最高,鞭虫渔民感染最高,贾第虫、溶组织阿米巴和带绦虫是牧民感染最高等等。”
在王老师的诱导式询问下,老刘这时候回想起来,早在2015年2月,他便作为一名挖金船管理员开始在位于非洲中部的刚果民主共和国工作,并在那里生活了整整一年。他还回忆道,在刚到非洲的时候,两只手上还对称地起了疱疹,当时没有在意,后来也就自己痊愈了。这一年中,非洲的蚊虫防不胜防,他反复被叮咬,即使防了又防,也无法幸免。

图1. 刚果(金)在非洲大陆的位置
(图片来源于网络)
这一旅居史为我们提供了有用的线索。再加上老刘本次发病为慢性病程,主要表现为臀部无痛性包块,曾有一过性腿部及全身红色皮疹,伴瘙痒,血常规、生化指标均未见明显异常,超声结果提示为炎症性病变伴皮下水肿。
王新宇老师分析道:“结合老刘术后病理镜下所见,我们综合考虑丝虫感染的可能性比较大,而感染时间应该就是在老刘在非洲工作的这段时间里。” 常见的非洲地区感染的丝虫有盘尾丝虫和罗阿丝虫,而证实究竟是哪一种则对医生的专业水平和能力是很大的考验。
紧接着,我们联合病理科的专家们一同对老刘的病理结果进行了更为详细的分析。镜下,苏木精和伊红染色染色发现成虫被纤维结节包裹。诊断的关键特征有角皮层具有明显的横纹,表皮环(黑色三角)、包含卷曲的微丝蚴的成对子宫分支(白色箭头)、肠道(黑色箭头)。这些病理特征符合盘尾丝虫的虫体特征。


图2. 手术后病理镜检
A. 苏木精和伊红染色显示数条盘尾丝虫成虫,包括一个完整的纵切面的成年雌性成虫(×40倍);
B. 横剖面示盘尾丝虫被炎症细胞包围(×400倍)
为了从基因上确认丝虫身份,我们对老刘手术的组织病理进行脱腊和DNA提取,用盘尾丝虫特异性PCR序列引物进行扩增,并进行了测序比对。该操作和刑侦部门搜集毛发或残骸,提取DNA检查确认身份的思路如出一辙。
至此,老刘的诊断终于明确:盘尾丝虫皮肤感染。
说到非洲归来的捉虫记,王新宇老师手中不止一个。著名的案例就是2017年非洲加蓬务工归来的老杨。他不慎被昆虫叮咬,之后出现皮疹和反复发热、头痛,回国后辗转国内多家医院却得不到诊断,之后甚至出现昏睡。
当地医生推荐老杨到华山医院感染科。华山医院感染科卢清教授在门诊接诊了老杨。
在简单的病史询问中,病人却睡着了数十次。卢教授意识到老杨得的可能是一种罕见感染性疾病,并且已经侵犯到大脑,随时会有生命危险,立即收入我科重症病房。
以张文宏主任、王新宇医生等为核心的华山感染热带病与旅行医学团队结合老杨从非洲返回并出现昏睡症状,立即想到了一个在中国非常罕见的传染病——非洲锥虫病!
检验科顾剑飞医生也很快在老杨的骨髓涂片找到了的元凶——布氏锥形虫!同样,当时也面临精准分型的问题。布氏锥形虫有两种,冈比亚锥形虫和罗得西亚锥形虫,两种锥形虫的治疗药物却截然不同。

图3. 血液中的锥虫(示意图)
图片来源于网络
图4. 患者骨髓中的锥虫(X1000倍)
鉴于锥虫病在国内极其罕见,特请我科最高“法官”翁心华教授一起探讨老杨病情,翁老分析老杨在加蓬被咬,而加蓬位于中非,根据流行病学患者感染布氏冈比亚锥虫的可能性大,这与患者的临床表现也吻合了起来!

图5. 查房中的翁心华教授
很快,寄生虫预防控制所传回的结果确认了翁教授的分析:布氏冈比亚锥虫抗体阳性!二代测序结果证实患者脑脊液中亦检测到布氏冈比亚锥虫。
诊断确诊,但这种病只见于非洲撒哈拉沙漠以南地区,不仅华山医院没有常备治疗药物,国内其他医院也没有。中国疾病预防控制中心寄生虫预防控制所周晓农教授,第一时间与位于瑞士日内瓦世界卫生组织总部相关专家取得联系。
由寄生虫预防控制所牵头,世卫组织总部、世卫组织北京办事处、华山医院感染科四方接入,召开“国际疑难病例讨论”电话会议。 经过半个多小时的讨论,病例得到WHO总部确认,并准许拨发药物。
凌晨三点,治疗的特效药物坐上了日内瓦直飞首都北京的航班!次日, WHO总部通知特效治疗药物已到北京!王新宇老师开出“救命药”入关所需处方!
第三天凌晨1点多,载着老杨的救命药物的航班到达上海虹桥机场T2航站楼,王新宇老师从中国CDC寄生虫预防控制所工作人员的手中接到过特效治疗药物,依氟鸟氨酸(Eflornithine)和硝呋替莫(Nifurtimox)!


图6. 世界卫生组织空运发放的药物
早上七点,治疗药物到达华山医院感染科重症病房,老杨有救了。经过7天依氟鸟氨酸静脉治疗和10天硝呋替莫口服治疗,老杨逐渐清醒了,并且能与家人简单交流。复查骨髓穿刺和腰椎穿刺都没有再找到布氏锥虫,病情逐渐平稳的老杨于2017年9月15日出院。王新宇老师嘱咐老杨定期复查腰穿,预防复发。此后,老杨来科里复查多次,恢复良好,未有复发。

图7. 医生们同老杨交流病情
(左起:徐斌、张文宏、卢清、顾剑飞、王新宇医生)
全面评估,绝不遗漏
回到老刘的故事。自从被确诊了寄生虫感染,虽然充分信任医生,但老刘仍时不时感到担忧,害怕自己身体里还有其他地方被这种从未听说过的寄生虫侵袭。为此,我们向他详细介绍了这位陌生的“访客”和我们的治疗决策。
盘尾丝虫病主要在撒哈拉沙漠以南的非洲地区流行,在阿拉伯半岛(也门)和美洲(巴西和委内瑞拉)也有小范围内的流行。被世界卫生组织列为重点防治的热带病之一。盘尾丝虫(Onchocerca volvulus)的传播主要通过蚋(ruì)属(Simulium spp),俗称黑蝇。含有丝虫感染期幼虫的蚋叮人吸血后造成感染,幼虫寄生于人体皮下组织内,可引起严重的眼部损害甚至失明,又称河盲症。
根据寄生虫的密度不同,临床表现可能出现在感染后数月甚至数年,常在离开流行区后。盘尾丝虫病最常见的皮肤的表现是剧痒的丘疹样病变,而长期病变可以包括萎缩、角化过度和色素沉着异常。幼虫侵入皮下组织后,蜕皮发育为成虫,而成虫致病的主要表现是在皮肤组织中。一开始患者出现数毫米大小的皮下结节,最常见于髋部,随着炎症反应的不断刺激,虫体周围逐渐纤维化使皮肤结节直径增大至数厘米。轻度感染者可能出现嗜酸性粒细胞或免疫球蛋白增多。
但相比于成虫,微丝蚴更为致命。长寿的雌性成虫可在人体内存活长达19年,产微丝蚴9~10年,每条雌虫一生中可产生数以百万计的微丝蚴。微丝蚴可能会引起皮炎、淋巴管炎和眼部病变,甚至导致视力损害和失明。微丝蚴所致皮肤损害类型多样,这是由于围绕死亡微丝蚴所产生的炎症反应以及抗原释放对人体组织的损伤。病变多为皮疹,初期症状为剧痒,后续可继发细菌感染导致皮肤色素沉着和苔藓样变。微丝蚴也可侵犯淋巴结,表现为为淋巴结肿大而坚实,不痛,内有大量的微丝蚴。微丝蚴进入眼球则可以引起眼部病变,可侵犯角膜,是盘尾丝虫病最严重的病损。同时盘尾丝虫也可以诱发癫痫,是非洲地区常见的继发性癫痫的病因。
盘尾丝虫病的诊断通常是基于皮肤活组织检查发现微丝蚴的存在,和切除的皮肤结节发现成虫虫体。经验丰富的寄生虫专家可根据镜下虫体的主要形态特征来诊断。然而, 由于非流行区的雌性成虫如果尚未开始产生微丝蚴,常常导致诊断困难。外周血高寄生虫血症患者可能在外周血中检出微丝蚴,但是较为罕见。血清学检测有助于鉴别诊断,然而血清学检测的缺点是特异性不够,存在一定的假阳性。其次,在非流行国家通常未储备相应的检测试剂盒。此外,分子诊断对这类疾病也有很高的诊断价值。

图8. 沉积于眼部的丝虫
(图片来源于Lancet Infectious Disease)
相比出生居住于盘尾丝虫流行区的患者,旅行至当地的感染者更常见皮肤微丝蚴和眼内感染,有的人短期停留2~6周就出现了感染。像老刘这样的长期在非洲工作生活,在疫区的驻留时间较长,更是重要的易感人群。针对眼睛等器官的检查,对老刘来说是十分重要的。
另一方面,目前尚不能排除老刘是否合并罗阿丝虫的感染,如果确有合并,那么草率使用治疗盘尾丝虫的伊维菌素将会促进罗阿丝虫的微丝蚴进入中枢神经系统,导致脑病,诱发癫痫,可能造成严重神经系统后遗症和死亡。
因此,我们对患者完善了头颅磁共振增强检查,未见明显异常。腰穿脑脊液检查显示:脑脊液澄清无色,红细胞:1×10^6/L,白细胞:1×10^6/L,糖:3.5 mmol/L,氯:120 mmol/L,蛋白:442 mg/L,未发现明显异常。眼科相关检测亦未见明显异常。基于这些检查,目前暂时可以排除盘尾丝虫对老刘脑部和眼部的累及。
长期随访,密切观察
盘尾丝虫感染的主要治疗药物是伊维菌素(ivermectin),口服剂量为12mg,能够显著减少皮肤内微丝蚴的数量,并抑制微丝蚴所致的皮炎,但不会杀死成虫。沃尔巴克体属(Wolbachia)是盘尾丝虫体内重要的共生菌,消灭沃尔巴克体属的治疗也是推荐的盘尾丝虫病的治疗方法,通常采用多西环素。一些专家建议患者服用一剂伊维菌素,序贯以6周多西环素的治疗方案。但直至2018年,国内尚无正规渠道可以获取伊维菌素,成为了治疗的障碍。
对于老刘而言,他的诊断已经明确,数次血检微丝蚴均为阴性,皮下结节也已切除,且眼、脑等器官评估均无明显异常,因此目前尚无微丝蚴感染的证据。考虑到药物的可及性和必要性,我们最终未予老刘伊维菌素治疗,给其使用了更为安全的多西环素6周疗程。
经过一年的密切随访,老刘无任何新发症状。
参考文献
1. Lipner EM, Law MA, Barnett E, et al. Filariasis in Travelers Presenting to the GeoSentinel Surveillance Network[J]. PLOS Neglected Tropical Diseases. 2007, 1(3): e88.
2. Mc Carthy JS, Ottesen EA, Nutmna TB. Onchocerciasis in endemic and non-endemic populations: differences in clinical presentation and immunologic findings[J]. The Journal of Infectious Diseases, 1994,170(3): 736-741.
3. Puente S, Ramirez-Olivencia G, Lago M, et al. Dermatological manifestations in onchocerciasis: A retrospective study of 400 imported cases[J]. Enferm Infecc Microbiol Clin,2017, 36(10):633-639.
4. Hoerauf A, Büttner D W, Adjei O, et al. Science, medicine, and the future: Onchocerciasis[J]. The BMJ, 2003, 326(7382): 207-210.
来源:华山感染
各科医生最讨厌啥?最后一个绝了!2020-08-20
老年痴呆提前34年就会有症状!做好这几件事,可大幅度降低风险!2020-08-17


点分享

